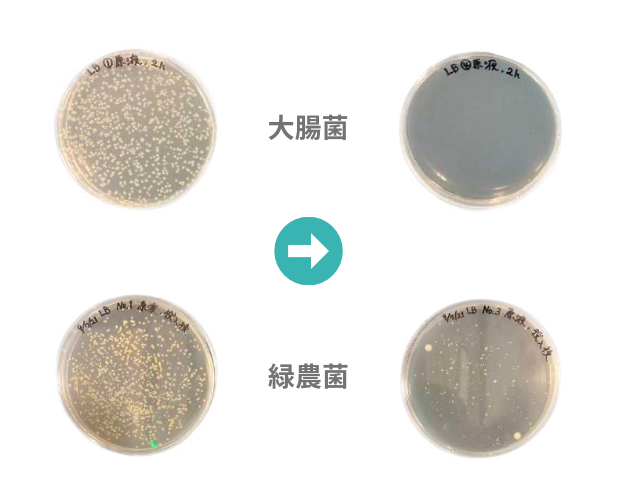

お花や植物の水質改善剤「siliteシリット®️」を新発売!
銀の効果で雑菌や藻の繁殖を抑える水質改善剤を紹介
愛知県豊橋市にあるハイドロカルチャー観葉植物の生産者である株式会社Green Walk(代表取締役 大林 智子)から新商品「silite シリット」銀の効果で雑菌や藻の繁殖を抑える水質改善剤を2023年4月20日から発売しております。

・新商品「silite シリット」とは?
国産の天然ゼオライトをAg Repeller技術を用いて銀を特殊コーディングした水質改善剤です。ゼオライトの特性と、銀の除菌効果により雑菌や藻の繁殖を抑制し水をキレイに保ちます。水を清潔に保つことで植物の吸水を助けます。
「silite シリット」の2つの効果
「silite シリット」を使用することで主に2つの効果があります。
①藻・雑菌の抑制

水(水道水)を入れた瓶にsiliteを入れて藻を添加するテストを3ヶ月間で実証実験を行いました。siliteなしの瓶は藻が繁殖していることがわかると思います。siliteありの瓶は3ヶ月後も藻が繁殖しておらず水(水道水)がキレイな状態が保たれていることがわかりました。
siliteを入れた水(10g/L)に大腸菌・緑膿菌を添加し、2時間後に溶液を採取。37℃で24時間培養して生菌数を確認する実証実験を行いました。siliteを入れると大腸菌・緑膿菌の数が大幅に減少し、水がキレイな状態が保たれていることがわかりました。
②植物の吸水を助ける

siliteを入れた花瓶と入れていない花瓶を用意し、切花の吸水テストを行いました。3日目からsiliteなしの花瓶のお花は萎れ始め、一方でsiliteを入れた花瓶では変化がありませんでした。10日目にはsiliteなしの花瓶のお花は枯れ始めました。siliteを入れた花瓶では変化がないことがわかりました。
詳しい実験データや紹介動画などは「silite シリット」ホームページ(https://silite-greenwalk.com/)に掲載しております。
「silite シリット」の活用方法
活用方法は主に2つです。
①「切花」での活用
siliteを入れると、雑菌が減少し、お花の切り口が清潔になり吸水しやすくなります。花瓶のヌメリや臭いの原因となる菌も減らすため、花瓶を手入れする手間が軽減します。siliteを使用することで、お花屋さんの作業時間の手助けとなります。
②ハイドロカルチャーの観葉植物で活用
siliteを入れることにより、藻の繁殖が抑えられ容器(鉢)の手入れが軽減されます。また、雑菌の増殖も抑制できるため根が傷むリスクが軽減します。ハイドロカルチャーは透明のガラス容器を用いることが多いですが、藻が繁殖して緑色になることを抑えることができます。
「siliteシリット」効果の推奨期間は約3ヶ月です。
1週間に1回、新しい水に交換して使用した場合の目安期間です。
使用方法や使用環境、花や植物の種類によって推奨期間が変わる場合があります。
11月15日〜17日に東京ビックサイトで開催されました、「フローラルイノベーション 2023」にて大盛況

2023年11月15日〜17日に東京ビックサイトで開催された「フローラルイノベーション 2023」に出展していました。会期中は、多くの方にお越しいただき大盛況でした。
ブースのデザインはこだわり、siliteを用いたお花での装飾、siliteを用いた観葉植物でおしゃれなカフェのイメージで作製しました。お花ですので会期後半になるにつれて萎れてきますが、siliteの効果で会期中の3日間は元気な状態で保つことができました。
2024年も関連の展示会に出展予定ですので、お越しください。
「silite シリット」の購入に関して

法人や園芸関係の方は、「silite シリット」ホームページのお問い合わせフォーム(https://silite-greenwalk.com/)よりお問い合わせください。
個人でご購入の際はタノシミドリ(https://www.rakuten.co.jp/tanoshimidori/)からお買い求めください。
【ご取材・商品に関するお問い合わせ】
株式会社Green Walk
〒441-8132 愛知県豊橋市南大清水町字元町61-2
E-MAIL:greenwalk@g-planet.com
担当:青山
【会社概要】
社名:株式会社Green Walk
所在地:愛知県豊橋市南大清水町字元町61-2
代表者:大林 智子
すべての画像
